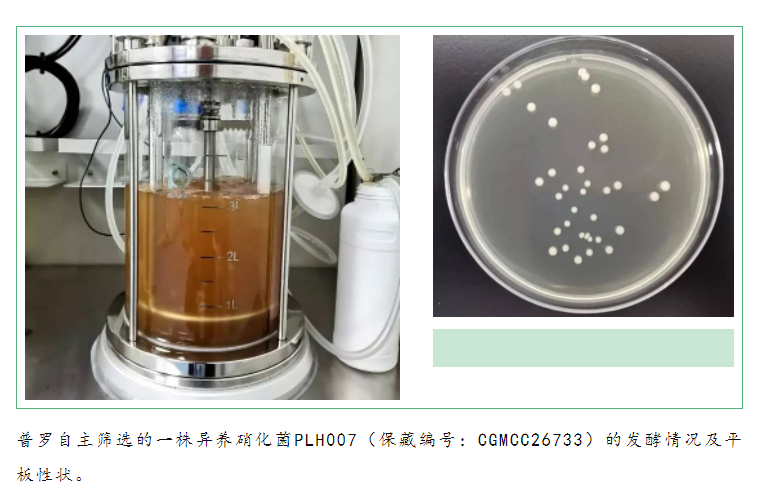
image.png

News
2023-05-08
普羅生物
1569
異養(yǎng)硝化菌的開發(fā)應(yīng)用是普羅研發(fā)中心重要研發(fā)方向之一,那么為什么要重點(diǎn)關(guān)注異養(yǎng)硝化菌呢?與傳統(tǒng)自養(yǎng)硝化菌相比,異養(yǎng)硝化菌的單位生物量的脫氨效率偏低,但由于其種類豐富、生長迅速,其總體脫氨效率并不慢。異養(yǎng)硝化菌具有較多自養(yǎng)硝化菌欠缺的優(yōu)勢,例如:對溶氧要求低、對環(huán)境適應(yīng)性強(qiáng)、能夠代謝各種形態(tài)的氮化合物、降解不同類型的COD等。研究發(fā)現(xiàn)不少異養(yǎng)硝化菌還能同步進(jìn)行好氧反硝化作用,即具有全程硝化反硝化的功能,以上優(yōu)點(diǎn)共同決定了異養(yǎng)硝化菌在廢水處理方面的極大潛力。

返回列表